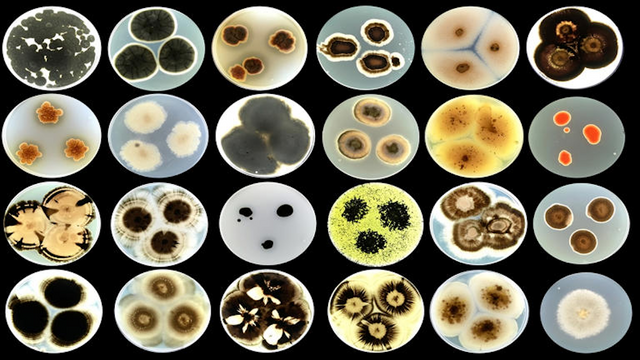

“Living tattoos” with microorganisms that transform facades into CO2 filters/“Tatuajes vivos” con microorganismos que transforman las fachadas en filtros de CO2
Source
Carbon dioxide remains the number one enemy of our society due to its role in increasing the greenhouse effect, which is why every so often, innovations emerge that attempt to mitigate this scourge. One of the most recent is the REMEDY project, funded by the European Innovation Council, which seeks to merge synthetic biology, materials science, and architectural design to transform cities into more sustainable and resilient environments.
El dióxido de carbono sigue siendo el enemigo número uno de nuestra sociedad por su papel en el aumento del efecto invernadero, por eso cada cierto tiempo aparece alguna innovación que intenta mitigar esta lacra. Uno de los más recientes el proyecto REMEDY, financiado por el Consejo Europeo de Innovación, que busca fusionar biología sintética, ciencia de materiales y diseño arquitectónico para transformar las ciudades en entornos más sostenibles y resilientes.
This project developed "living tattoos," a biotechnological innovation that involves applying a living ink composed of selected microorganisms to building facades. These microorganisms are integrated into the coatings, transforming the walls into active surfaces capable of capturing carbon dioxide from the air, filtering atmospheric pollutants, and even repairing surface cracks in building materials.
En este proyecto se han desarrollado unos “tatuajes vivos”, una innovación biotecnológica que consiste en aplicar una tinta viva, compuesta por microorganismos específicos seleccionados, sobre las fachadas de los edificios. Estos microorganismos son integrados en los revestimientos permitiendo que las paredes se conviertan en superficies activas, capaces de capturar dióxido de carbono del aire, filtrar contaminantes atmosféricos y hasta reparar grietas superficiales en los materiales de construcción.

Source
Its application uses a printed living ink containing microorganisms carefully selected for their ability to perform beneficial ecological functions. This ink is applied precisely and customizable, allowing the type and distribution of microorganisms to be tailored to the needs of the building being treated or the urban environment. These microorganisms are certain photosynthetic algae or bacteria that absorb atmospheric CO2 during their metabolism, reducing the carbon footprint of cities.
Para su aplicación se utiliza una tinta viva impresa, que contiene microorganismos cuidadosamente seleccionados por su capacidad para realizar funciones ecológicas beneficiosas. Esta tinta se aplica de manera precisa y personalizable, lo que permite adaptar el tipo y la distribución de microorganismos según las necesidades del edificio a tratar o del entorno urbano. Estos microorganismos son ciertas algas o bacterias fotosintéticas que absorben el CO2 atmosférico durante su metabolismo, reduciendo la huella de carbono de las ciudades.
In addition to absorbing carbon dioxide, these microorganisms can also absorb and degrade other pollutants present in urban air, thereby improving environmental quality without the need for additional electrical systems. Some microorganisms can even contribute to the repair of microcracks that occur in facades, prolonging the lifespan of materials and avoiding the use of toxic coatings.
Además de absorber el dióxido de carbono estos microorganismos también pueden absorber degradar otros contaminantes que están presentes en el aire de las ciudades, mejorando de esta manera la calidad ambiental sin necesidad de sistemas eléctricos adicionales. Algunos microorganismos incluso pueden contribuir a la raparación de las microgrietas que se producen en las fachadas, prolongando la vida útil de los materiales y evitando el uso de recubrimientos tóxicos.

Source
The "living tattoos" for facades are in an advanced stage of research and development, but the team is working on formulating biological inks compatible with inkjet printing systems, which poses a significant technical challenge, as the microorganisms must survive the process and remain functional under varying environmental conditions. Development requires pilot tests in real buildings to evaluate performance under different climatic and urban conditions.
Los “tatuajes vivos” para fachadas están en una fase avanzada de investigación y desarrollo, pero el equipo está trabajando en la formulación de tintas biológicas compatibles con sistemas de impresión de inyección de tinta y eso es un reto técnico importante, ya que los microorganismos deben sobrevivir al proceso y mantenerse funcionales en condiciones ambientales variables. El desarrollo requiere ensayos piloto en edificios reales para evaluar el rendimiento en distintas condiciones climáticas y urbanas.
Although the technology has massive application potential, with 9.4 billion square meters of facades and roofs undergoing renovation or construction in the European Union over the next 25 years, it is not yet ready for immediate commercial use in private homes. The first pilot applications in experimental buildings and pioneering urban projects are expected to be seen in the coming years, probably before 2030, so I fear we will still have to wait.
Aunque la tecnología tiene un potencial de aplicación masiva, con 9,4 mil millones de metros cuadrados de fachadas y tejados en proceso de renovación o construcción en la Unión Europea en los próximos 25 años, aún no está lista para su uso comercial inmediato en viviendas particulares. Las previsiones son que las primeras aplicaciones piloto en edificios experimentales y proyectos urbanos pioneros puedan verse en los próximos años, probablemente antes de 2030, así que me temo que aún tendremos que esperar.
More information/Más información
https://interestingengineering.com/innovation/living-tattoos-for-buildings-fight-pollution